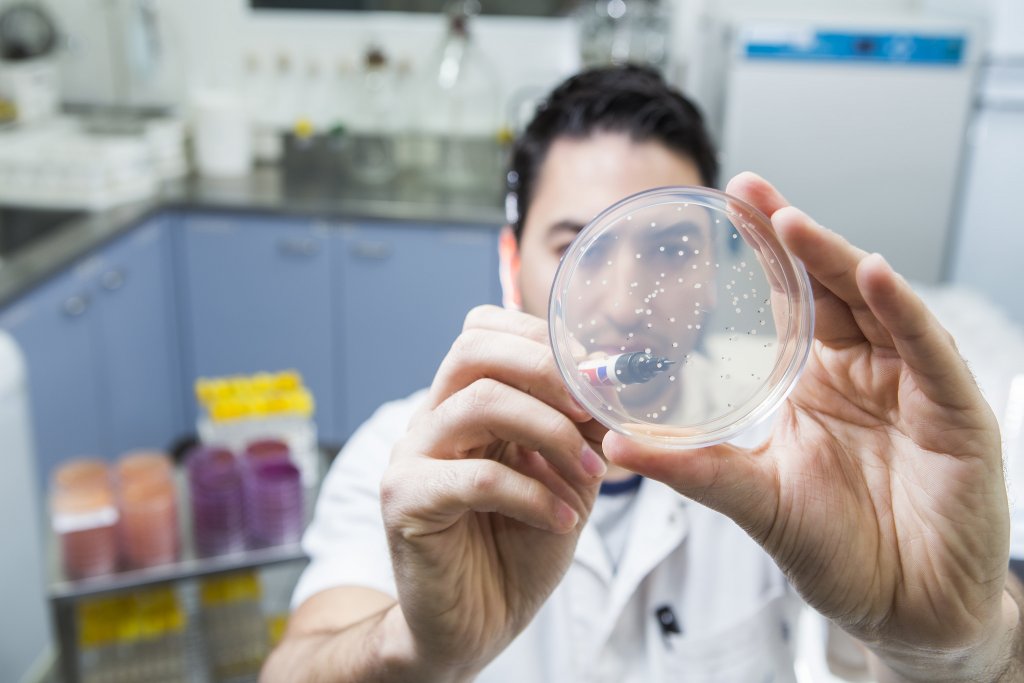

La siembra de soja está próxima a comenzar en Argentina y una de las principales preocupaciones de los productores es cómo enfrentar las labores de implantación en un escenario de sequía que afecta a casi todas las zonas agrícolas del país.
Un aspecto clave, en este contexto, es fortalecer el cultivo en materia nutricional, para que pueda responder de mejor manera ante el estrés hídrico.
Según Juan Catracchia, jefe de Producto de Inoculantes Soja y Terápicos de Rizobacter, un dato importante a tener en cuenta es que entre el 60% y el 80% del nitrógeno que consume una planta de la oleaginosa, surge de la nodulación.

Por ello, es un proceso fisiológico esencial, ya que ese nutriente es uno de los principales determinantes para la definición de rendimiento del cultivo.
“Por este motivo es que es tan importante elegir productos de calidad y tecnologías de vanguardia tanto en inoculantes como en terápicos, así como hacer una correcta aplicación. Más aún ante una campaña estival que se anticipa nuevamente con falta de agua”, subraya Catracchia.
CINCO OPCIONES PARA POTENCIAR LA SOJA
Bajo este panorama, Rizobacter ofrece cinco diferentes tecnologías que apuntan a acercar la soja a su potencial de rendimiento, aún en un contexto de escasez hídrica.
LIQ. Un tratamiento para inocular las semillas a campo y en el día.
TOP. Una tecnología de osmoprotección, que marcó un hito en el mercado de inoculantes ya que permitió hacer un preinoculado, sin necesidad de agregar un protector bacteriano externo.
“Es un trabajo que se hace en laboratorio sobre la bacteria: se logra engrosar su pared celular y eso le permite perder humedad a mucha menor tasa. También posibilita que los terápicos entren a menor tasa, lo cual te da una menor mortandad de bacterias”, explicó Catracchia.

SIGNUM. En 2012, Rizobacter recibió el premio CITA a la Innovación Tecnológica, por este desarrollo con una tecnología de bioinducción.
Catracchia describió al respecto que en la primera etapa del proceso de la nodulación, la bacteria y la planta se reconocen a través de la quimiotaxis; y que en dicho proceso, ambas secretan señales químicas que hacen que se reconozcan y así se produzca la infección.
“Lo que hicimos fue aislar esos precursores químicos y los pusimos en el inoculante Signum. De esa manera, logramos nodulaciones de manera anticipada en el ciclo del cultivo y así ya aseguramos la captura de N atmosférico aún en situaciones desfavorables”, remarcó.
Por esa razón, la tecnología sirve para garantizar nodulaciones más tempranas y en condiciones de estrés o limitantes para la bacteria, como puede ser un suelo muy seco o ácido. “Este año, en este contexto de falta de humedad, desde lo técnico recomendamos el uso de Signum”, señaló Catracchia.

DAKAR. Es un producto que se obtuvo por medio de una selección natural inducida de bacterias, entre las que se escogieron dos cepas a las que sometieron a alta temperatura y baja humedad relativa, luego multiplicaron a las que sobrevivieron y finalmente las escalaron en un biofermentador.
“Son bacterias especialmente adaptadas para ambientes de alta temperatura de suelo y baja humedad relativa como el norte del país o Sudáfrica, contextos mucho más complicados en los cuales estas bacterias rustificadas performan mejor. Esta tecnología también tiene mucho para aportarnos este año de déficit hídrico”, agregó el representante de Rizobacter.
LLI. Es la abreviación de Long Life Inoculant: una tecnología de larga vida que ofrece la posibilidad de hacer el tratamiento con gran anticipación, facilitando la operatividad. En concreto, permite 90 días de preinoculado y, cuando se le agrega el terápico, ya pasó por 60 días de preinoculado.
“Al tener un preinoculado tan largo, hoy tenemos un market share enorme en todo lo que es industria, semilleros y grandes compañías para el tratamiento de semillas. Las principales compañías nos están comprando todo a nosotros, porque es muy innovador y tiene una mayor carga bacteriana por mililitro de producto. Rizobacter tiene la mayor UFC (Unidad Formadora de Colonias) del mercado”, mencionó Catracchia.
Uno de los sellos distintivos de la tecnología LLI es que es un tratamiento profesional en el que se puede agregar la cantidad exacta de ingrediente activo que se determine en cada semilla porque “las máquinas están confeccionadas para eso, es bastante distinto al tratamiento que hace a campo el productor”.
“Con el tratamiento profesional de semillas buscamos industrializar el proceso que normalmente se realiza a campo y nos permite una dosificación exacta, logramos aplicar y distribuir de manera uniforme los productos, tenemos mayor control de patógenos y sanidad del cultivo, optimizamos los tiempos de trabajo, logramos un control y profesionalización en los procesos, es más sustentable y amigable con el medio ambiente entre otros atributos”, cerró el técnico de la empresa oriunda de Pergamino.
MÁS INFORMACIÓN, AQUÍ

























